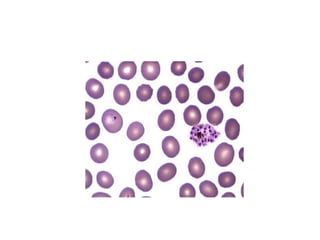
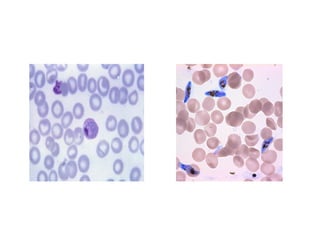

The document details a case of malaria in a 48-year-old male, highlighting symptoms like high fever, chills, and profuse sweating, and discusses the causative agents including Plasmodium vivax and Plasmodium falciparum. It outlines the complex life cycle of the parasite, clinical features, pathogenesis, types of malarial fever, and potential complications of falciparum malaria. Additionally, it describes laboratory diagnostic methods and the recommended treatments for both vivax and falciparum malaria, along with prevention strategies.




![Definitive Host
•Female Anopheles
mosquito [sexual phase]
Intermediate Host
•Man [ asexual phase]](https://image.slidesharecdn.com/malaria-211002173958/85/Malaria-5-320.jpg)